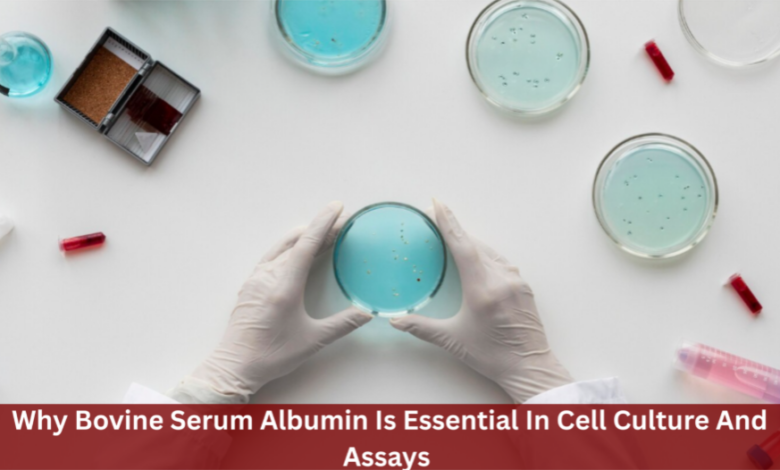
Cell culture and assay procedures

Cell culture and assay procedures demand consistent conditions, but even most experiments suffer from unstable proteins, inconsistent cell responses, and…
Read More »Uncategorized
Productivity in the contemporary workplace is a multifaceted construct, often influenced by a range of individual and organizational factors. Among…
Read More »Decades ago, during simpler times, Canadians would pass the time by escaping to a family cottage, going hunting/fishing, enjoying outdoor…
Read More »Holidays are meant to be joyful, refreshing, and full of memories. But when things go wrong at the last minute,…
Read More »In the dynamic world of material processing, efficiency and precision play pivotal roles in the success of a project. The…
Read More »Online betting has changed the way people have fun with games where you use luck or skill. You do not…
Read More »When it comes to maintaining a comfortable and healthy indoor environment, few systems are as vital as heating, ventilation, and…
Read More »Traveling offers a chance to explore new cultures, experience breathtaking landscapes, and create unforgettable memories. While many destinations around the…
Read More »Designing a living room that strikes the perfect balance between functionality and style is a goal for many homeowners. It’s…
Read More »In an interconnected commercial world, businesses increasingly rely on external vendors, suppliers, and service providers to support their day-to-day operations.…
Read More »